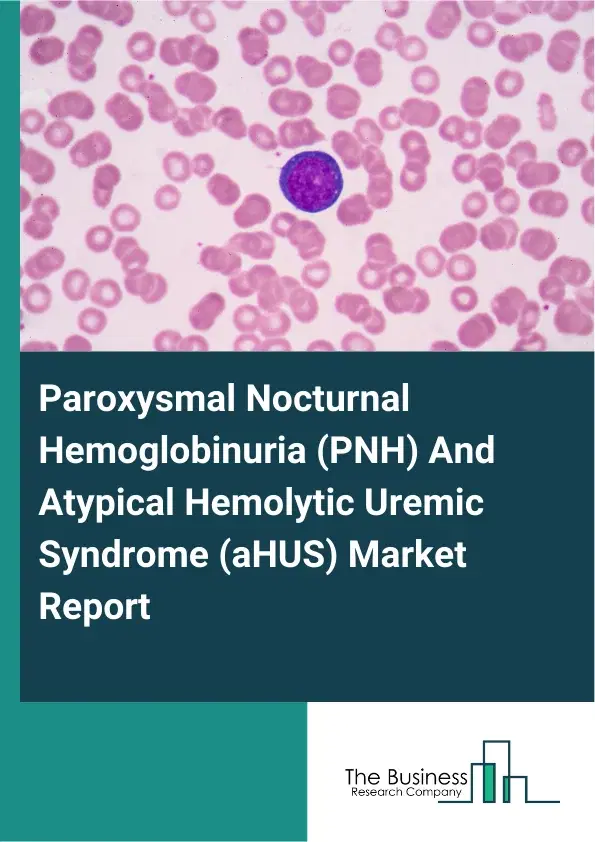
Global Paroxysmal Nocturnal Hemoglobinuria (PNH) And Atypical Hemolytic Uremic Syndrome (aHUS) Market Report 2026 Global Paroxysmal Nocturnal Hemoglobinuria (PNH) And Atypical Hemolytic Uremic Syndrome (aHUS) Market Report 2026

Paroxysmal Nocturnal Hemoglobinuria (PNH) And Atypical Hemolytic Uremic Syndrome (aHUS) Market Report 2026
Global Outlook – By Type (Soliris, Ultomiris), By Disease Type (Paroxysmal Nocturnal Hemoglobinuria(PNH), Atypical Hemolytic Uremic Syndrome(aHUS)), By Treatment Type (Complement Inhibitors, Plasma Exchange Or Infusion, Other Symptomatic Treatments), By Diagnosis Method (Clinical Diagnosis, Genetic Testing, Biomarker Testing), By End-User (Hospitals, Specialty Clinics, Research Institutes, Other End-Users) - Market Size, Trends, And Global Forecast 2026-2035
Paroxysmal Nocturnal Hemoglobinuria (PNH) And Atypical Hemolytic Uremic Syndrome (aHUS) Market Overview
• Paroxysmal Nocturnal Hemoglobinuria (PNH) And Atypical Hemolytic Uremic Syndrome (aHUS) market size has reached to $5.97 billion in 2025 • Expected to grow to $8.42 billion in 2030 at a compound annual growth rate (CAGR) of 7.1% • Growth Driver: Rising Prevalence Of Rare Diseases Fueling The Growth Of The Market Due To Advancements In Diagnostic Technologies And Increasing Awareness • Market Trend: Development Of Complement Inhibitors Revolutionizing PNH And aHUS Treatment With Enhanced Patient Convenience And Outcomes • North America was the largest region in 2025 and Asia-Pacific is the fastest growing region.What Is Covered Under Paroxysmal Nocturnal Hemoglobinuria (PNH) And Atypical Hemolytic Uremic Syndrome (aHUS) Market?
Paroxysmal nocturnal hemoglobinuria (PNH) and atypical hemolytic uremic syndrome (aHUS) refer to rare, life-threatening blood disorders caused by uncontrolled activation of the complement system, a part of the immune system. Paroxysmal nocturnal hemoglobinuria (PNH) leads to the destruction of red blood cells, while atypical hemolytic uremic syndrome (aHUS) causes blood clots in small blood vessels, primarily affecting the kidneys and other vital organs. The main types of paroxysmal nocturnal hemoglobinuria (PNH) and atypical hemolytic uremic syndrome (aHUS) include soliris, and ultomiris. Soliris refers to a monoclonal antibody medication, also known by its generic name eculizumab, that is used to treat rare, life-threatening blood disorders such as paroxysmal nocturnal hemoglobinuria (PNH) and atypical hemolytic uremic syndrome (aHUS). The various disease types include paroxysmal nocturnal hemoglobinuria (PNH) and atypical hemolytic uremic syndrome (aHUS), and treatment types involved are complement inhibitors, plasma exchange or infusion, and others. The multiple diagnosis methods are clinical diagnosis, genetic testing, and biomarker testing and are used by several end-users, such as hospitals, specialty clinics, research institutes, and others.
What Is The Paroxysmal Nocturnal Hemoglobinuria (PNH) And Atypical Hemolytic Uremic Syndrome (aHUS) Market Size and Share 2026?
The paroxysmal nocturnal hemoglobinuria (pnh) and atypical hemolytic uremic syndrome (ahus) market size has grown strongly in recent years. It will grow from $5.97 billion in 2025 to $6.41 billion in 2026 at a compound annual growth rate (CAGR) of 7.3%. The growth in the historic period can be attributed to limited availability of targeted complement therapies, delayed diagnosis due to disease rarity, reliance on plasma exchange and supportive care, high treatment costs restricting access, low awareness of complement-mediated disorders.What Is The Paroxysmal Nocturnal Hemoglobinuria (PNH) And Atypical Hemolytic Uremic Syndrome (aHUS) Market Growth Forecast?
The paroxysmal nocturnal hemoglobinuria (pnh) and atypical hemolytic uremic syndrome (ahus) market size is expected to see strong growth in the next few years. It will grow to $8.42 billion in 2030 at a compound annual growth rate (CAGR) of 7.1%. The growth in the forecast period can be attributed to development of next-generation complement inhibitors, increasing diagnosis rates through advanced testing, growing focus on orphan disease drug development, expansion of reimbursement coverage for rare diseases, rising establishment of specialty hematology and nephrology centers. Major trends in the forecast period include rising adoption of complement inhibitor therapies, increasing use of genetic and biomarker testing, growth of long-acting complement inhibition drugs, expansion of specialized rare disease treatment centers, improved early diagnosis of complement-mediated disorders.Global Paroxysmal Nocturnal Hemoglobinuria (PNH) And Atypical Hemolytic Uremic Syndrome (aHUS) Market Segmentation
1) By Type: Soliris, Ultomiris 2) By Disease Type: Paroxysmal Nocturnal Hemoglobinuria(PNH), Atypical Hemolytic Uremic Syndrome(aHUS) 3) By Treatment Type: Complement Inhibitors, Plasma Exchange Or Infusion, Other Symptomatic Treatments 4) By Diagnosis Method: Clinical Diagnosis, Genetic Testing, Biomarker Testing 5) By End-User: Hospitals, Specialty Clinics, Research Institutes, Other End-Users Subsegments: 1) By Soliris: Eculizumab For PNH, Eculizumab For aHUS, Eculizumab Biosimilars 2) By Ultomiris: Ravulizumab For PNH, Ravulizumab For aHUS, Ravulizumab Extended-Interval DosingWhat Is The Driver Of The Paroxysmal Nocturnal Hemoglobinuria (PNH) And Atypical Hemolytic Uremic Syndrome (aHUS) Market?
The rising prevalence of rare diseases is expected to propel the growth of the paroxysmal nocturnal hemoglobinuria (PNH) and atypical hemolytic uremic syndrome (aHUS) market going forward. Rare diseases are medical conditions that affect a small percentage of the population, typically fewer than 200,000 individuals, and are often characterized by their complexity, severity, and the need for specialized treatment. The increasing prevalence of rare diseases can be attributed to advancements in diagnostic technologies, which enable better detection and identification of previously underreported or undiagnosed conditions. Paroxysmal nocturnal hemoglobinuria (PNH) and atypical hemolytic uremic syndrome (aHUS) contribute to the understanding and treating rare diseases by providing insights into the pathophysiology and potential therapeutic targets for conditions with limited treatment options. For instance, in November 2024, according to the Food and Drug Administration, a US-based federal agency, more than 7,000 rare diseases impacted over 30 million individuals in the United States. Therefore, the rising prevalence of rare diseases is driving the growth of the paroxysmal nocturnal hemoglobinuria (PNH) and atypical hemolytic uremic syndrome (aHUS) industry.Key Players In The Global Paroxysmal Nocturnal Hemoglobinuria (PNH) And Atypical Hemolytic Uremic Syndrome (aHUS) Market
Major companies operating in the paroxysmal nocturnal hemoglobinuria (pnh) and atypical hemolytic uremic syndrome (ahus) market are Roche Holding AG, Alexion Pharmaceuticals Inc, Genentech Inc, Novartis AG, Apellis Pharmaceuticals Inc, Omeros Corporation, BioCryst Pharmaceuticals Inc, ChemoCentryx Inc, Sanofi SA, CSL Behring, Takeda Pharmaceutical Company, Pfizer Inc, Regeneron Pharmaceuticals Inc, Ionis Pharmaceuticals Inc, Horizon Therapeutics, Achillion Pharmaceuticals Inc, Sobi Swedish Orphan Biovitrum AB, ImmunoForge Co Ltd, Care Pharma, Daiichi Sankyo Co Ltd, Astellas Pharma Inc, Mallinckrodt Pharmaceuticals, CANbridge Pharmaceuticals Inc.Global Paroxysmal Nocturnal Hemoglobinuria (PNH) And Atypical Hemolytic Uremic Syndrome (aHUS) Market Trends and Insights
Major companies operating in the paroxysmal nocturnal hemoglobinuria (PNH) and atypical hemolytic uremic syndrome (aHUS) market are focusing on developing innovative products, such as complement inhibitors, to improve treatment outcomes and patient convenience. Complement inhibitors are therapeutic agents that block specific components of the complement system, a part of the immune system that helps clear pathogens and damaged cells. For instance, in December 2023, Novartis AG, a Switzerland-based pharmaceutical company, received U.S. Food and Drug Administration (FDA) approval for Fabhalta (iptacopan), the first oral monotherapy for the treatment of adults with paroxysmal nocturnal hemoglobinuria, and provides superior hemoglobin improvement without the need for transfusions. This innovative complement inhibitor works by inhibiting Factor B in the alternative complement pathway, providing comprehensive control of both intravascular and extravascular hemolysis. Its oral administration simplifies disease management and improves the quality of life for patients, eliminating the burdens associated with frequent infusions.What Are Latest Mergers And Acquisitions In The Paroxysmal Nocturnal Hemoglobinuria (PNH) And Atypical Hemolytic Uremic Syndrome (aHUS) Market?
In January 2025, Samsung Bioepis Co. Ltd., a South Korea-based biopharmaceutical company, partnered with Teva Pharmaceutical Industries Ltd. This partnership aims to develop and commercialize the Soliris (eculizumab) biosimilar and EPYSQLI (eculizumab-aagh), a biosimilar for rare diseases, with the aim of increasing access to affordable treatment options for U.S. patients. Teva Pharmaceutical Industries Ltd. is an Israel-based pharmaceutical company that develops, manufactures, and commercializes medicines for various rare diseases, including paroxysmal nocturnal hemoglobinuria (PNH) and atypical hemolytic uremic syndrome (aHUS).Regional Outlook
North America was the largest region in the paroxysmal nocturnal hemoglobinuria (PNH) and atypical hemolytic uremic syndrome (aHUS) market in 2025. Asia-Pacific is expected to be the fastest-growing region in the forecast period. The regions covered in this market report are Asia-Pacific, South East Asia, Western Europe, Eastern Europe, North America, South America, Middle East, Africa. The countries covered in this market report are Australia, Brazil, China, France, Germany, India, Indonesia, Japan, Taiwan, Russia, South Korea, UK, USA, Canada, Italy, Spain.What Defines the Paroxysmal Nocturnal Hemoglobinuria (PNH) And Atypical Hemolytic Uremic Syndrome (aHUS) Market?
The paroxysmal nocturnal hemoglobinuria (PNH) and atypical hemolytic uremic syndrome (aHUS) market consists of revenues earned by entities by providing services such as bone marrow biopsy, flow cytometry testing, and multidisciplinary care coordination. The market value includes the value of related goods sold by the service provider or included within the service offering. The paroxysmal nocturnal hemoglobinuria (PNH) and atypical hemolytic uremic syndrome (aHUS) market also includes sales of flow cytometry reagents, anticoagulants, and pegcetacoplan. Values in this market are ‘factory gate’ values, that is the value of goods sold by the manufacturers or creators of the goods, whether to other entities (including downstream manufacturers, wholesalers, distributors and retailers) or directly to end customers. The value of goods in this market includes related services sold by the creators of the goods.How is Market Value Defined and Measured?
The market value is defined as the revenues that enterprises gain from the sale of goods and/or services within the specified market and geography through sales, grants, or donations in terms of the currency (in USD unless otherwise specified). The revenues for a specified geography are consumption values that are revenues generated by organizations in the specified geography within the market, irrespective of where they are produced. It does not include revenues from resales along the supply chain, either further along the supply chain or as part of other products.What Key Data and Analysis Are Included in the Paroxysmal Nocturnal Hemoglobinuria (PNH) And Atypical Hemolytic Uremic Syndrome (aHUS) Market Report 2026?
The paroxysmal nocturnal hemoglobinuria (pnh) and atypical hemolytic uremic syndrome (ahus) market research report is one of a series of new reports from The Business Research Company that provides market statistics, including industry global market size, regional shares, competitors with the market share, detailed market segments, market trends and opportunities, and any further data you may need to thrive in the paroxysmal nocturnal hemoglobinuria (pnh) and atypical hemolytic uremic syndrome (ahus) industry. The market research report delivers a complete perspective of everything you need, with an in-depth analysis of the current and future state of the industry.Paroxysmal Nocturnal Hemoglobinuria (PNH) And Atypical Hemolytic Uremic Syndrome (aHUS) Market Report Forecast Analysis
| Report Attribute | Details |
|---|---|
| Market Size Value In 2026 | $6.41 billion |
| Revenue Forecast In 2035 | $8.42 billion |
| Growth Rate | CAGR of 7.3% from 2026 to 2035 |
| Base Year For Estimation | 2025 |
| Actual Estimates/Historical Data | 2020-2025 |
| Forecast Period | 2026 - 2030 - 2035 |
| Market Representation | Revenue in USD Billion and CAGR from 2026 to 2035 |
| Segments Covered | Type, Disease Type, Treatment Type, Diagnosis Method, End-User |
| Regional Scope | Asia-Pacific, Western Europe, Eastern Europe, North America, South America, Middle East, Africa |
| Country Scope | The countries covered in the report are Australia, Brazil, China, France, Germany, India, ... |
| Key Companies Profiled | Roche Holding AG, Alexion Pharmaceuticals Inc, Genentech Inc, Novartis AG, Apellis Pharmaceuticals Inc, Omeros Corporation, BioCryst Pharmaceuticals Inc, ChemoCentryx Inc, Sanofi SA, CSL Behring, Takeda Pharmaceutical Company, Pfizer Inc, Regeneron Pharmaceuticals Inc, Ionis Pharmaceuticals Inc, Horizon Therapeutics, Achillion Pharmaceuticals Inc, Sobi Swedish Orphan Biovitrum AB, ImmunoForge Co Ltd, Care Pharma, Daiichi Sankyo Co Ltd, Astellas Pharma Inc, Mallinckrodt Pharmaceuticals, CANbridge Pharmaceuticals Inc. |
| Customization Scope | Request for Customization |
| Pricing And Purchase Options | Explore Purchase Options |
